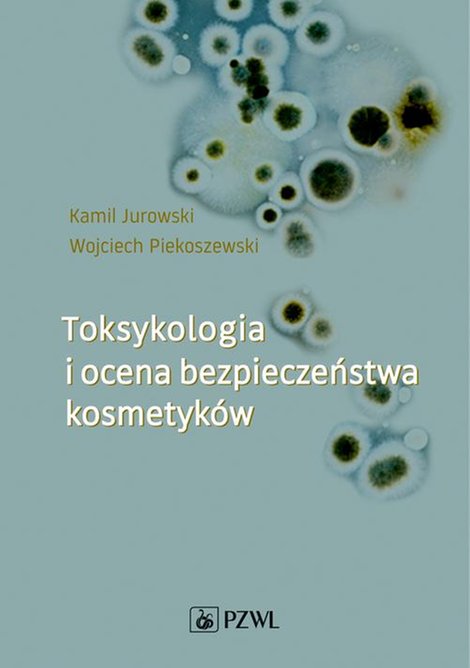
ebooki: Toksykologia i ocena bezpieczeństwa kosmetyków – ebook

Toksykologia i ocena bezpieczeństwa kosmetyków – ebook
Opis
Książka, jakiej jeszcze nie było na polskim rynku wydawniczym! Autorzy w sposób kompleksowy przedstawiają aspekty zarówno teoretyczne, jak i praktyczne w zakresie toksykologii i oceny bezpieczeństwa kosmetyków. Całość podzielono na trzy części: podstawy toksykologii ogólnej, toksykologię kosmetyków i ocenę bezpieczeństwa. Niezbędnik dla studentów kosmetologii, chemii kosmetycznej, chemii, biochemii, biotechnologii oraz dermatologów, alergologów, poczatkujących safety assessorów i praktyków.
Opinie o produkcie
Bądź pierwszą osobą, która doda opinię!